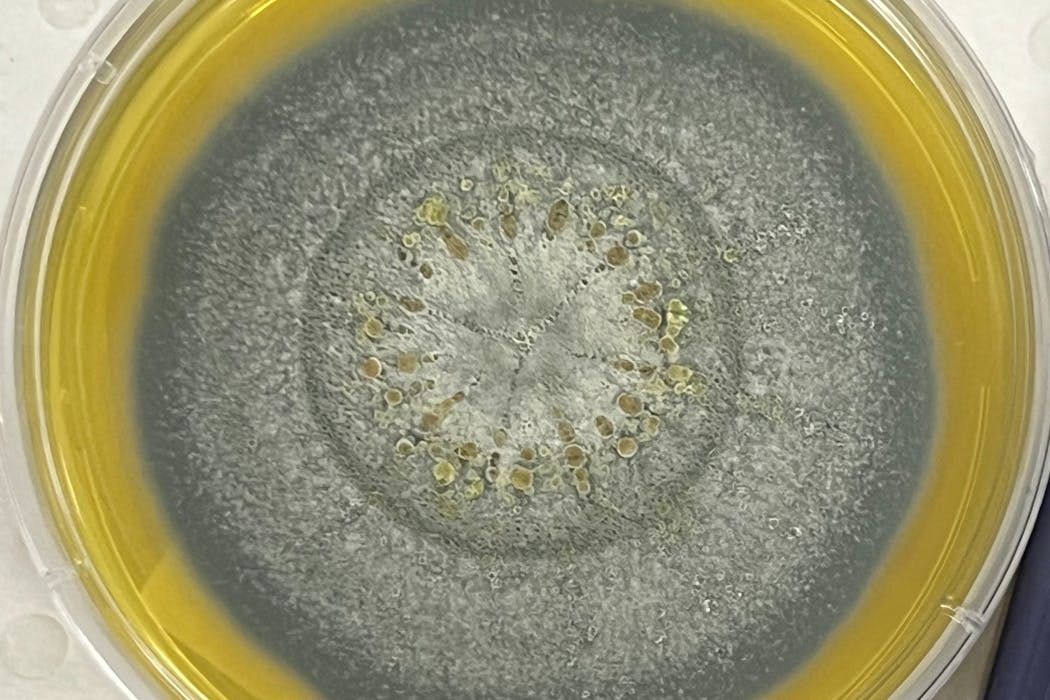

A common mould has killed two people, and left four others seriously ill, at one of Sydney’s largest hospitals.
Health authorities a cluster of fungal infections at the Royal Prince Alfred Hospital’s transplant unit.
Six patients developed infections between October and December 2025 after being exposed to Aspergillus, a common mould found in soil, plants, dust and damp environments.
In a statement, a hospital spokesperson suggested the mould may have been present at nearby construction sites, part of the hospital’s A$940 million redevelopment.
So what is Aspergillus? And should you be concerned?
It’s a common mould?
Yes. Aspergillus moulds are a type of filamentous fungi, meaning they form long chains, and are usually found in soil, plants and damp areas.
This type of mould is usually harmless to healthy people. But it can cause a severe respiratory disease called aspergillosis. Aspergillosis affects about 250,000 people around the world.
How can Aspergillus harm?
This type of mould produces airborne spores, which people may inhale into their lungs.
There, these spores can cause an infection in the smallest chambers of the lungs. This is because they release toxins and enzymes that damage lung tissue. These spores can spread to other parts of the body such as the brain, kidneys, heart or skin, causing further infection.
Symptoms of an infection include fever, cough and chest pain. You may have trouble breathing or might start coughing up blood. Aspergillus can also cause skin and eye infections.
Read more: Global deaths from fungal disease have doubled in a decade – new study
Who is most vulnerable?
Our immune systems can generally fight Aspergillus infections. But people with weakened immune systems have a much higher risk of developing an infection.
These include people having chemotherapy, corticosteroid treatment, or organ or stem cell transplants. Transplant patients are particularly vulnerable. This is because their immune system must be deliberately weakened to stop their body rejecting the transplanted organ. If they somehow inhale Aspergillus spores, the fungus can more easily take hold in their lungs.
Read more: Deadly drug-resistant fungus spreading rapidly through European hospitals
Dormant spores in the lungs of transplant patients may also cause infection when the spores are activated. But health authorities did not indicate this occurred at the Sydney hospital.
One large US study found just 59% of organ transplant recipients and 25% of stem cell transplant patients were still alive one year after developing invasive aspergillosis.
People with asthma may develop allergies to Aspergillus even if their immune systems are healthy. And it can cause severe allergic reactions in people with cystic fibrosis, a genetic condition in which sticky mucus blocks their airways. People with other lung conditions such as tuberculosis, influenza or COVID are also at a higher risk of developing an Aspergillus infection.
What are the treatment options?
Aspergillus can be treated with antifungal drugs such as itraconazole and corticosteroids. This treatment is most effective when we detect the infection early.
But researchers have identified strains of Aspergillus that don’t respond to this kind of treatment. So antifungal resistance is an urgent problem.
What else do I need to know?
Aspergillus infections are relatively uncommon in the general population. And they are rare in hospitals, where wards and rooms are usually fitted with high-efficiency particulate air, or HEPA, filters. These filters capture and remove potentially harmful particles from the air.
However, construction work may disturb the soil near or around the hospital, releasing a high number of Aspergillus spores into the air. This increases the risk of hospitals having clusters of infection. It remains unclear whether this is what happened at The Royal Prince Alfred Hospital.
Read more: Almost half of antibiotic prescribing for surgery is inappropriate, new report shows
The authors do not work for, consult, own shares in or receive funding from any company or organisation that would benefit from this article, and have disclosed no relevant affiliations beyond their academic appointment.
This article was originally published on The Conversation. Read the original article.